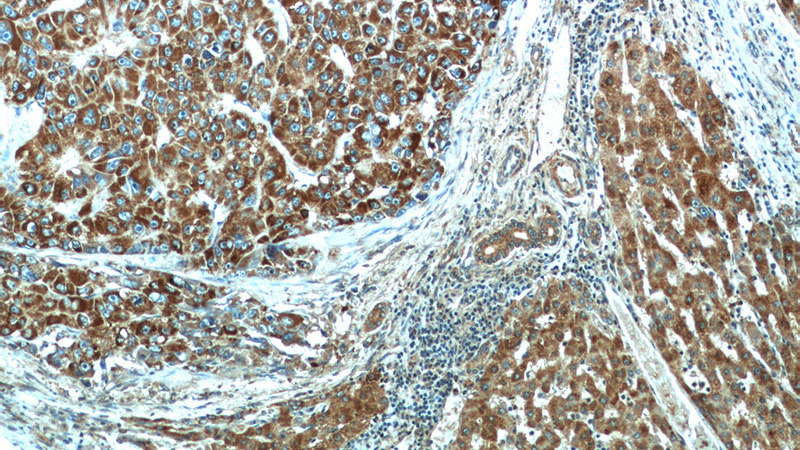
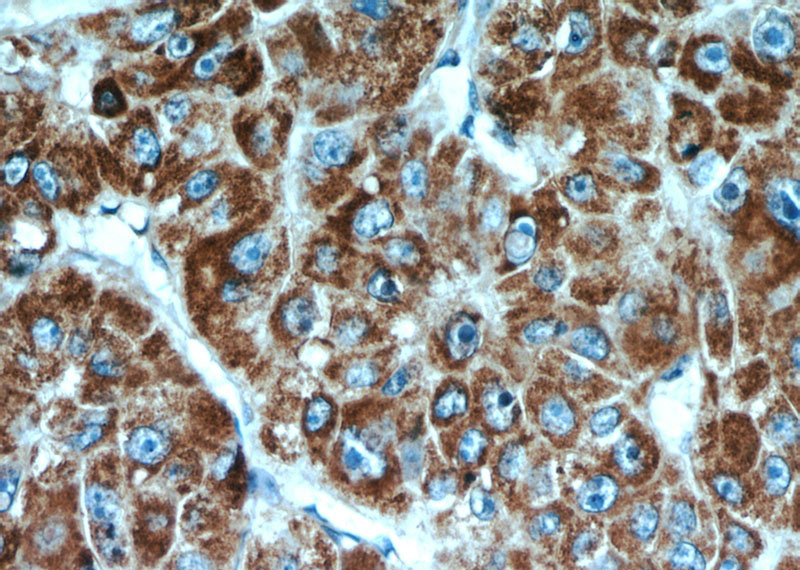

-
Product Name
CPT1A antibody
- Documents
-
Description
CPT1A Rabbit Polyclonal antibody. Positive IF detected in Hela cells. Positive IHC detected in human liver cancer tissue, human kidney tissue. Positive FC detected in HeLa cells. Positive WB detected in HepG2 cells, A549 cells, human heart tissue, human kidney tissue, L02 cells, MCF7 cells, mouse kidney tissue, mouse liver tissue, rat kidney tissue. Positive IP detected in HepG2 cells. Observed molecular weight by Western-blot: 86 kDa
-
Tested applications
ELISA, WB, IF, IP, IHC, FC
-
Species reactivity
Human,Mouse,Rat; other species not tested.
-
Alternative names
CPT I antibody; CPT1 antibody; CPT1 L antibody; CPT1A antibody; CPTI L antibody; L CPT1 antibody
-
Isotype
Rabbit IgG
-
Preparation
This antibody was obtained by immunization of CPT1A recombinant protein (Accession Number: NM_001031847). Purification method: Antigen affinity purified.
-
Clonality
Polyclonal
-
Formulation
PBS with 0.02% sodium azide and 50% glycerol pH 7.3.
-
Storage instructions
Store at -20℃. DO NOT ALIQUOT
-
Applications
Recommended Dilution:
WB: 1:500-1:5000
IP: 1:200-1:1000
IHC: 1:20-1:200
IF: 1:10-1:100
-
Validations

WB results of CPT1A antibody (1:1000) with shCPT1A-A549 and shCPT1A-HepG2 cells. shControl-A549 and shControl-HepG2 as positive control.
Immunohistochemical of paraffin-embedded human liver cancer using Catalog No:109530(CPT1A antibody) at dilution of 1:100 (under 10x lens)
Immunohistochemical of paraffin-embedded human liver cancer using Catalog No:109530(CPT1A antibody) at dilution of 1:100 (under 40x lens)

Immunofluorescent analysis of Hela cells, using CPT1A antibody Catalog No:109530 at 1:25 dilution and Rhodamine-labeled goat anti-rabbit IgG (red).

HepG2 cells were subjected to SDS PAGE followed by western blot with Catalog No:109530(CPT1A antibody) at dilution of 1:1000

IP Result of anti-CPT1A (IP:Catalog No:109530, 3ug; Detection:Catalog No:109530 1:300) with HepG2 cells lysate 2000ug.

1X10^6 HeLa cells were stained with 0.2ug CPT1A antibody (Catalog No:109530, red) and control antibody (blue). Fixed with 90% MeOH blocked with 3% BSA (30 min). Alexa Fluor 488-congugated AffiniPure Goat Anti-Rabbit IgG(H+L) with dilution 1:1000.
-
Background
CPT1A, also named as CPT1, CPT1-L and L-CPTI, belongs to the carnitine/choline acetyltransferase family. It is Localized Chromosome 11q13.1-2. Carnitine palmitoyltransferase (CPT) deficiencies are common disorders of mitochondrial fatty acid oxidation. The CPT system is made up of two separate proteins located in the outer (CPT1) and inner (CPT2) mitochondrial membranes. CPT1A is an active forms of related liver-type carnitine palmitoyltransferase I. (PMID: 11001805). CPT1A deficiency presents as recurrent attacks of fasting hypoketotic hypoglycemia. (PMID: 15363638). This antibody can bind the close sequences genes.
-
References
- Patella F, Schug ZT, Persi E. Proteomics-based metabolic modeling reveals that fatty acid oxidation (FAO) controls endothelial cell (EC) permeability. Molecular & cellular proteomics : MCP. 14(3):621-34. 2015.
- Namgaladze D, Lips S, Leiker TJ. Inhibition of macrophage fatty acid β-oxidation exacerbates palmitate-induced inflammatory and endoplasmic reticulum stress responses. Diabetologia. 57(5):1067-77. 2014.
- Joshi M, Eagan J, Desai NK. A compound heterozygous mutation in GPD1 causes hepatomegaly, steatohepatitis, and hypertriglyceridemia. European journal of human genetics : EJHG. 22(10):1229-32. 2014.
- Shearn CT, Backos DS, Orlicky DJ, Smathers-McCullough RL, Petersen DR. Identification of 5' AMP-activated kinase as a target of reactive aldehydes during chronic ingestion of high concentrations of ethanol. The Journal of biological chemistry. 289(22):15449-62. 2014.
- Li S, Zhou T, Li C. High metastaticgastric and breast cancer cells consume oleic acid in an AMPK dependent manner. PloS one. 9(5):e97330. 2014.
- Namgaladze D, Brüne B. Fatty acid oxidation is dispensable for human macrophage IL-4-induced polarization. Biochimica et biophysica acta. 1841(9):1329-35. 2014.
- Huang D, Li T, Li X. HIF-1-mediated suppression of acyl-CoA dehydrogenases and fatty acid oxidation is critical for cancer progression. Cell reports. 8(6):1930-42. 2014.
- Ji AT, Chang YC, Fu YJ, Lee OK, Ho JH. Niche-dependent regulations of metabolic balance in high-fat diet-induced diabetic mice by mesenchymal stromal cells. Diabetes. 64(3):926-36. 2015.
Related Products / Services
Please note: All products are "FOR RESEARCH USE ONLY AND ARE NOT INTENDED FOR DIAGNOSTIC OR THERAPEUTIC USE"
